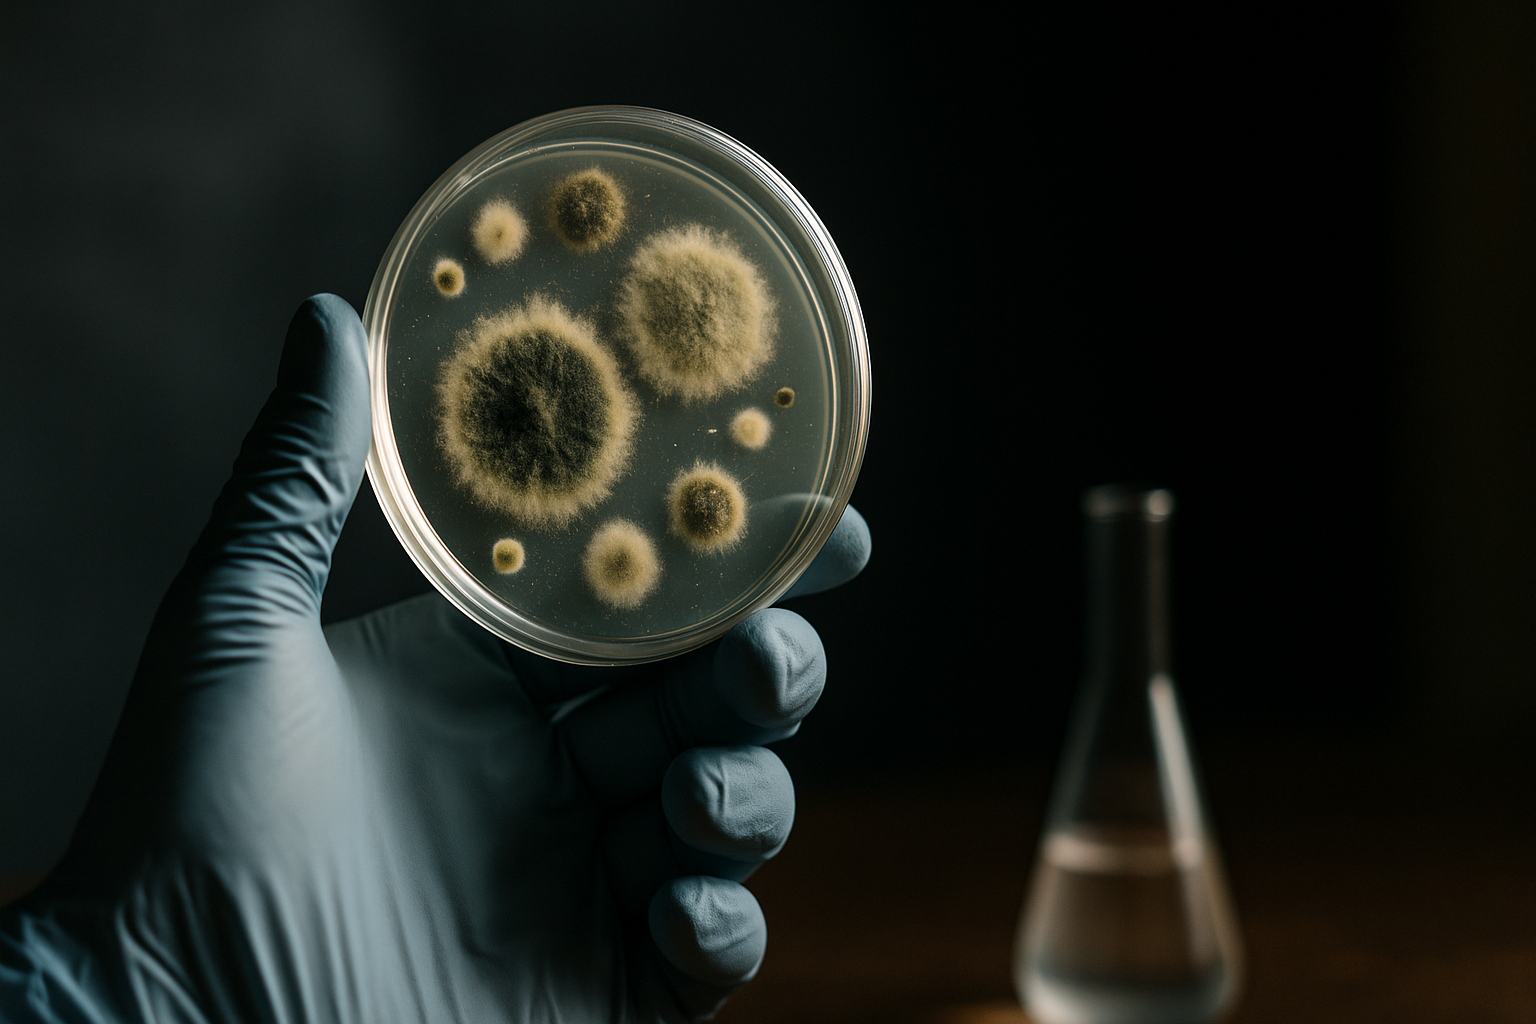

Table of Contents
Understanding Mold and Mycotoxins
The mold mycotoxin test is an essential tool for detecting hazardous mold and the mycotoxins they produce. Mold refers to a group of fungi that grow indoors commonly in warm and humid indoor environments, such as those found in Dubai’s climate. When mold grows unchecked, it can release mycotoxins, toxic chemical substances harmful to human health. Understanding these risks is key to maintaining safe and healthy indoor air quality in homes and workplaces throughout Dubai. A precise mold mycotoxin test is indispensable for confirming their presence.
Mycotoxins affect indoor air quality and can cause respiratory problems, allergic reactions, and other serious medical conditions, especially when individuals are exposed to them over time. The presence of mold and mycotoxins in the environment underlines the importance of an effective mold mycotoxin test as part of a comprehensive prevention strategy.
Why a Mold Mycotoxin Test Is Critical
Using a mold mycotoxin test allows property owners in Dubai to identify invisible mold spores and mycotoxins that could remain undetected by visual inspection alone. This test analyzes air and surface samples to detect both living mold and residual mycotoxins, offering a holistic view of contamination.
Early detection through a mold mycotoxin test enables timely remediation before contamination worsens. Relying on a professional mold mycotoxin test helps secure evidence for effective remediation strategies. This approach protects the health of occupants and preserves property values. Furthermore, Dubai Municipality’s environmental regulations encourage proactive mold management in buildings to reduce health risks and maintain public hygiene standards.
Common Sources of Mold Contamination in Dubai
Despite Dubai’s arid climate, indoor mold is a common concern due to high humidity in certain areas, water leaks, and inadequate ventilation. Typical sources of mold contamination include:
- Air conditioning systems that are not regularly maintained.
- Water leaks and seepage in bathrooms and kitchens.
- Poorly ventilated spaces, especially basements and storage rooms.
- Building materials that retain moisture, such as drywall and carpets.
- Condensation on windows and walls during seasonal humidity fluctuations.
Spotting these sources early and performing a mold mycotoxin test after any suspected exposure can prevent long-term contamination.
10 Effective Prevention Tips for Mold Mycotoxin Contamination
To protect your Dubai property and health, here are ten actionable tips to prevent mold and mycotoxin contamination:
- Regular Inspection: Regularly inspect your property, especially hidden areas vulnerable to moisture buildup, and schedule periodic mold mycotoxin tests. Such tests provide data essential for targeted prevention and remediation.
- Control Humidity: Keep indoor humidity below 60% using dehumidifiers and maintain efficient air conditioning in locations such as Business Bay and Dubai Marina.
- Fix Leaks Promptly: Repair leaks in plumbing, roofs, and windows immediately to prevent mold growth behind walls or under floors.
- Ventilate Effectively: Use exhaust fans and open windows to promote air circulation in kitchens and bathrooms.
- Maintain HVAC Systems: Clean and service air conditioning units regularly to prevent mold spores circulation throughout your premises.
- Use Mold-Resistant Materials: Consider moisture-resistant building supplies when renovating.
- Keep Surfaces Dry: Wipe down wet surfaces and avoid leaving wet fabrics or carpets damp.
- Limit Indoor Plants: Overwatering indoor plants can increase indoor humidity and mold growth; manage watering carefully.
- Professional Mold Testing: Utilize professional mold mycotoxin test services in Dubai for accurate detection and risk assessment.
- Educate Occupants: Inform family members, tenants, or staff about mold prevention practices and signs to watch for.
How to Choose a Reliable Mold Mycotoxin Test Service in Dubai
When selecting a mold mycotoxin test service in Dubai, consider the following criteria:
- Accreditation and Experience: Choose laboratories accredited by Dubai Health & Safety and with a proven track record in mold testing.
- Comprehensive Testing: Ensure tests cover both mold spores and mycotoxin detection for full-spectrum assessment.
- Clear Reporting: The service should provide detailed, easily understandable reports including risk mitigation advice.
- Local Knowledge: Select companies familiar with Dubai’s climatic challenges and regulatory standards, such as Saniservice Dubai.
- Customer Support: Responsive customer service helps answer queries and organize follow-up services.
When seeking effective solutions, always ensure the chosen provider offers a comprehensive mold mycotoxin test. For a trusted resource on professional mold mycotoxin test services, visit 800molds, a Dubai-based specialist offering such services adhering strictly to local standards.
The Role of Dubai Health Authorities in Mold Control
Dubai Municipality along with Dubai Health Authority (DHA) actively regulate indoor environmental safety, emphasizing measures against mold contamination. The authorities mandate regular inspections in hospitality and residential sectors to safeguard occupant health.
They provide guidelines encouraging building owners to conduct mold mycotoxin tests and act swiftly on identified risks. Additionally, these authorities collaborate with testing laboratories and remediation companies to ensure effective mold management practices aligned with public health objectives. They also advocate for widespread adoption of the mold mycotoxin test among property managers.
Understanding and complying with these regulations not only ensures legal conformity but also promotes healthier living environments across Dubai localities like Nad Al Sheba or Arabian Ranches.
Conclusion and Actionable Steps
Preventing mold and mycotoxin contamination is a smart investment in your health and property longevity in Dubai’s unique environment. A mold mycotoxin test is a critical component of any prevention and remediation strategy, enabling early detection and targeted intervention.
Implementing the 10 prevention tips discussed recognizes the specific challenges of Dubai’s climate and construction practices. Leveraging expert testing services and adhering to Dubai Municipality guidelines for mold mycotoxin test compliance will ensure a safer indoor environment.
Don’t wait for mold problems to escalate. Act now by scheduling a mold mycotoxin test and following best practices for moisture control. A prompt mold mycotoxin test is your first line of defense. Protect your home or business from the hidden dangers of mold and its toxic byproducts with informed decisions and expert support.